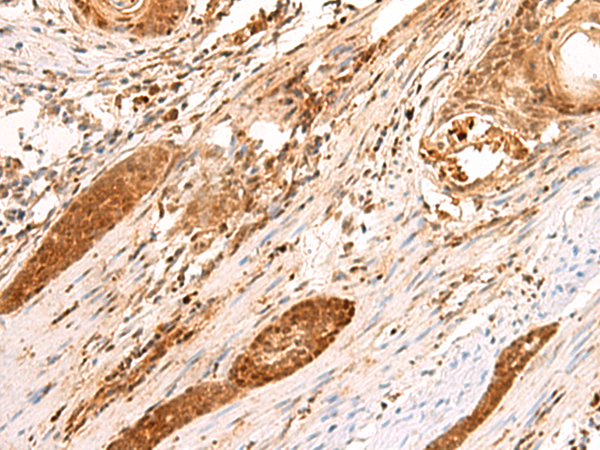
一抗

中文名稱: 兔抗SCAND1多克隆抗體
英文名稱: Anti-SCAND1 rabbit polyclonal antibody
別 名: SCAN domain containing 1; RAZ1; SDP1
相關(guān)類別: 一抗
儲 存: 冷凍(-20℃)
宿 主: Rabbit
抗 原: SCAND1
反應(yīng)種屬: Human
標(biāo) 記 物: Unconjugate
克隆類型: rabbit polyclonal
技術(shù)規(guī)格
|
Background: |
This gene encodes a SCAN box domain-containing protein. The SCAN domain is a highly conserved, leucine-rich motif of approximately 60 aa originally found within a subfamily of zinc finger proteins. This gene belongs to a family of genes that encode an isolated SCAN domain, but no zinc finger motif. This protein binds to and may regulate the function of the transcription factor myeloid zinc finger 1B. Alternate splicing results in multiple transcript variants. |
|
Applications: |
ELISA, IHC |
|
Name of antibody: |
SCAND1 |
|
Immunogen: |
Fusion protein of human SCAND1 |
|
Full name: |
SCAN domain containing 1 |
|
Synonyms: |
RAZ1; SDP1 |
|
SwissProt: |
P57086 |
|
ELISA Recommended dilution: |
5000-10000 |
|
IHC positive control: |
Human esophagus cancer |
|
IHC Recommend dilution: |
50-300 |

 購物車
購物車 幫助
幫助
 021-54845833/15800441009
021-54845833/15800441009